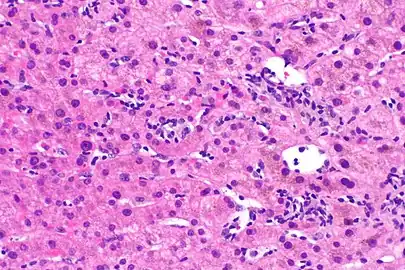
Lobular inflammation

Metabolic dysfunction–associated steatotic liver disease
| Metabolic dysfunction–associated steatotic liver disease | |
|---|---|
| Other names | MASLD, Non-alcoholic fatty liver disease (NAFLD),[1] Metabolic (dysfunction) associated fatty liver disease, MAFLD[2] |
 | |
| Stages of metabolic dysfunction–associated steatotic liver disease, progressing from healthy, to steatosis (fat accumulation), inflammation, fibrosis and cirrhosis. | |
| Specialty | Hepatology |
| Symptoms | Asymptomatic in the early stages In later stages: * Deposits of cholesterol on the eye lids * Fatigue * Crusty red nodules * Digestive issues Lastly causes liver disease and eventually liver failure |
| Complications | Cirrhosis, liver cancer, liver failure, cardiovascular disease[3][4] |
| Duration | Long term |
| Types | Metabolic dysfunction–associated steatotic liver (MASL), Metabolic dysfunction-associated steatohepatitis (MASH)[4][5] |
| Causes | Genetic, environmental |
| Risk factors | Obesity, metabolic syndrome, type 2 diabetes mellitus, liver disease |
| Diagnostic method | Ultrasound, Coexisting metabolic disorders, Liver biopsy |
| Treatment | Weight loss (in case of obesity) Dietary reduction of fructose and glucose[6] (diet and exercise)[4][7] |
| Prognosis | Depends on type[8] |
| Frequency | 24% in worldwide population, 80% in obese, 20% in normal-weight |
| Deaths | MASH: 2.6% risk of death per year[5] MAFL: Unknown[9] |
Metabolic dysfunction–associated steatotic liver disease (MASLD) is the name adopted in 2023 for the condition previously known as non-alcoholic fatty liver disease (NAFLD).[lower-alpha 1] This condition is diagnosed when there is excessive fat build-up in the liver (hepatic steatosis), and at least one metabolic risk factor.[1][3][4] When there is also moderate alcohol use, the term MetALD is used, and these are differentiated from alcoholic liver disease (ALD) when this is the sole cause of steatotic liver disease.[1][12] The terms non-alcoholic fatty liver (NAFL) and non-alcoholic steatohepatitis (NASH, now MASH) have been used to describe different severities, the latter indicating the presence of further liver inflammation.[4][5][8] NAFL is less dangerous than NASH and usually does not progress to it,[4] but this progression may eventually lead to complications, such as cirrhosis, liver cancer, liver failure, and cardiovascular disease.[4][13]
Obesity and type 2 diabetes are strong risk factors for MASLD.[7] Other risks include being overweight, metabolic syndrome (defined as at least three of the five following medical conditions: abdominal obesity, high blood pressure, high blood sugar, high serum triglycerides, and low serum HDL cholesterol), a diet high in fructose, and older age.[4][8] Obtaining a sample of the liver after excluding other potential causes of fatty liver can confirm the diagnosis.[3][7][8]
Treatment for MASLD is weight loss by dietary changes and exercise;[5][14][15] bariatric surgery can improve or resolve severe cases.[14][16] Although no drugs are approved to treat MASLD,[17] there is some evidence for GLP-1 agonists, pioglitazone, and vitamin E.[18] Those with MASH have a 2.6% increased risk of dying per year.[5]
MASLD is the most common liver disorder in the world; about 25% of people have it.[19] It is very common in developed nations, such as the United States, and affected about 75 to 100 million Americans in 2017.[20][21][22][23] Over 90% of obese, 60% of diabetic, and up to 20% of normal-weight people develop MASLD.[24][25] MASLD was the leading cause of chronic liver disease[23][24] and the second most common reason for liver transplantation in the United States and Europe in 2017.[14] MASLD affects about 20 to 25% of people in Europe.[16] In the United States, estimates suggest that 30% to 40% of adults have MASLD, and about 3% to 12% of adults have MASH.[4] The annual economic burden was about US$103 billion in the United States in 2016.[24]
Definition
An abnormal accumulation of fat in the liver in the absence of secondary causes of fatty liver, such as significant alcohol use, viral hepatitis, or medications that can induce fatty liver, was the definition of NAFLD.[19] However, the term MASLD accepts there may be other conditions present, but focuses on the metabolic abnormalities contributing to the disorder.[1][12] MASLD encompasses a continuum of liver abnormalities, from metabolic dysfunction–associated steatotic liver (MASL, simple steatosis) to Metabolic dysfunction-associated steatohepatitis (MASH). These diseases begin with fatty accumulation in the liver (hepatic steatosis). A liver can remain fatty without disturbing liver function (MASL), but by various mechanisms and possible insults to the liver, it may also progress into steatohepatitis (MASH), a state in which steatosis is combined with inflammation and sometimes fibrosis.[1] MASH can then lead to complications such as cirrhosis and hepatocellular carcinoma.[3][5][26]
The new name, metabolic dysfunction-associated steatotic liver disease (MASLD), was proposed after 70% of a panel of experts expressed support for this name.[1] This new name was adopted in 2023.[1][10]
Signs and symptoms
People with MASLD often have no noticeable symptoms, and it is often only detected during routine blood tests or unrelated abdominal imaging or liver biopsy.[5][26] In some cases, it can cause symptoms related to liver dysfunction such as fatigue, malaise, and dull right-upper-quadrant abdominal discomfort. Mild yellow discoloration of the skin may occur, although this is rare.[27] MASH can severely impair liver function, leading to cirrhosis, liver failure, and liver cancer.[5]
Comorbidities
The condition is strongly associated with or caused by type 2 diabetes, insulin resistance, and metabolic syndrome (defined as at least three of the five following medical conditions: abdominal obesity, high blood pressure, high blood sugar, high serum triglycerides, and low serum high-density lipoprotein). It is also associated with hormonal disorders (panhypopituitarism, hypothyroidism, hypogonadism, polycystic ovary syndrome), persistently elevated transaminases, increasing age, and hypoxia caused by obstructive sleep apnea; some of these conditions predict disease progression.[3][7][13][28][20][24][29]
Most normal-weight people with MAFLD ("lean MAFLD") have impaired insulin sensitivity, are sedentary, and have increased cardiovascular disease risk and increased liver lipid levels. These are the consequences of a decreased capacity for storing fat and reduced mitochondrial function in fat and increased hepatic de novo lipogenesis.[7][24] A recent systematic review reported an increased risk of severe COVID-19 infection in MAFLD patients, but no difference in mortality was observed between MAFLD and non-MAFLD patients.[30]
Risk factors
Genetics
Two-thirds of families with a history of diabetes type 2 report more than one family member having MASLD. There is a higher risk of fibrosis for family members where someone was diagnosed with MASH.[26] Asian populations are more susceptible to metabolic syndrome and MASLD than their western counterparts.[7] Hispanic persons have a higher prevalence of MASLD than white individuals, whereas the lowest prevalence is observed in black individuals.[24] MASLD is twice as prevalent in men as in women,[5] which might be explained by lower levels of estrogen in men.[31]
Genetic variations in two genes are associated with MASLD: non-synonymous single-nucleotide polymorphisms (SNPs) in PNPLA3 and TM6SF2. Both correlate with MASLD presence and severity, but their roles for diagnosis remain unclear.[24][32] Although NAFLD has a genetic component, the American Association for the Study of Liver Diseases (AASLD) does not recommend screening family members as there is not enough confirmation of heritability,[5] although there is some evidence from familial aggregation and twin studies.[24]
From diet
According to the Asia-Pacific Working Group (APWG) on MASLD, overnutrition is a major factor of MASLD and MASH, particularly for lean MAFLD.[7] Diet composition and quantity, in particular omega-6 fatty acid and fructose, have important roles in disease progression from MASL to MASH and fibrosis.[33][34] Choline deficiency can lead to the development of MASLD.[35]
Higher consumption of processed, red, and organ meats have been associated with higher risk of developing MASLD.[36][37][38] Some research also suggests eggs are also associated with developing MASLD.[39][40] On the other hand, studies have found healthful plant foods such as legumes and nuts, to be associated with a lower risk of developing MASLD.[41][42] Two different studies have found healthy plant-based diets rich in healthy plant foods and low in animal foods to be associated with a lower risk of developing MASLD, even after adjusting for BMI.[43][44]
From lifestyle
Habitual snoring may be a risk factor for MAFLD. Severe snoring often signals the presence of obstructive sleep apnea (OSAS), a much more serious breathing condition. Blockage or narrowing of the airways, even temporarily, can cause the body to experience lowered oxygen levels in the blood. This in turn may cause a variety of changes within the body such as tissue inflammation, increased insulin resistance, and liver injury.[45] A prospective cohort study found the association between habitual snoring and MASLD development to be significant, and the trend was noted to be most prominent in lean individuals.[46]
Pathophysiology
The primary characteristic of MASLD is the accumulation of lipids in the liver, largely in the form of triglycerides.[19] However, the mechanisms by which triglycerides accumulate and the reasons that accumulation can lead to liver dysfunction are complex and incompletely understood.[19][47][48] MASLD can include steatosis along with varied signs of liver injury: either lobular or portal inflammation (a form of liver injury) or ballooning degeneration. Similarly, NASH can include histological features such as portal inflammation, polymorphonuclear cell infiltrates, Mallory bodies, apoptotic bodies, clear vacuolated nuclei, microvesicular steatosis, megamitochondria, and perisinusoidal fibrosis.[16] Hepatocyte death via apoptosis or necroptosis is increased in MASH compared with simple steatosis, and inflammation is a hallmark of MASH.[32]
One debated mechanism proposes that hepatic steatosis progresses to steatosis with inflammation following some further injury, or second hit. Oxidative stress, hormonal imbalances, and mitochondrial abnormalities are potential causes of this "second hit" phenomenon.[26] A further nutrigenomics model named multiple hit extends the second hit model, suggesting that multiple disease biomarkers and factors such as genes and nutrition influence NAFLD and NASH progression. This model attempts to use these factors to predict the impact of lifestyle changes and genetics for the evolution of the NAFLD pathology.[49] Many researchers describe NAFLD as a multisystem disease, as it impacts and is influenced by organs and regulatory pathways other than the liver.[50][51][52]
The accumulation of senescent cells in the liver is seen in persons with NAFLD.[53] In mice, liver senescent hepatocytes result in increased liver fat deposition.[53] Treatment of NAFLD mice with senolytic agents has been shown to reduce hepatic steatosis.[53]
Based on gene knockout studies in murine models, it has been suggested that, among many other pathogenic factors, TGF beta signals may be crucially involved in promoting the progression of NASH.[54]
Fructose consumption
Non-alcoholic and alcoholic fatty liver disease share similar histological features, which suggests that they might share common pathogenic pathways. Fructose can cause liver inflammation and addiction similarly to ethanol by using similar metabolic pathways, unlike glucose. Therefore, some researchers argue that non-alcoholic and alcoholic fatty liver diseases are more alike than previously thought.[33][55] Furthermore, high fructose consumption promotes fat accumulation in the liver by stimulating de novo lipogenesis in the liver and reducing the beta-oxidation of fat.[19] Unlike the sugar glucose, the enzyme fructokinase rapidly metabolizes fructose. This leads to a decreased level of intracellular adenosine triphosphate (ATP).[19] The decrease in ATP increases oxidative stress and impairments in proper protein synthesis and mitochondrial function in the liver.[19]
Insulin resistance
Insulin resistance contributes to the accumulation of toxic fat in the liver in several ways. First, it promotes the release of free fatty acids (FFAs) from adipose tissue into the blood. Typically, adipose tissue stores lipids in the form of triglycerides, slowly releasing them into the bloodstream when insulin is low. In insulin-resistant adipose tissue, such as in people with obesity and type 2 diabetes, more triglycerides are broken down into FFAs and released into the bloodstream, promoting uptake by the liver.[19] Second, insulin promotes the production of new FFAs in the liver via de novo lipogenesis; this production of liver fats continues to be stimulated by insulin, even when other tissues are insulin-resistant.[19] These FFAs are combined back into triglycerides in the liver, forming the major constituent of the accumulated fat in the liver.[19] The three sources of free fatty acids that contribute to liver triglyceride accumulation include FFAs circulating in the bloodstream (59%), FFAs derived from carbohydrates such as fructose and glucose (26%), and diet (14%).[19] Despite the accumulation of triglycerides in the liver, they are not directly toxic to liver tissue.[19] Instead, alteration of the profile of the other lipid subtypes present in the liver, such as diacylglycerols, phospholipids, ceramides, and free cholesterol, have a more significant role in the pathogenesis of MAFLD.[19]
Once NAFLD progresses in severity to the point of NASH, this promotes further insulin resistance in the adipose tissue and liver, which results in a harmful cycle of insulin resistance, liver fat accumulation, and inflammation.[19] Adipose tissue dysfunction also decreases secretion of the insulin-sensitizing adipokine adiponectin in people with NAFLD.[19] Adiponectin has several properties that protect the liver.[19] These properties include improved liver fat metabolism, decreased de novo lipogenesis, decreased glucose production in the liver, anti-inflammatory properties, and anti-fibrotic properties.[19] Skeletal muscle insulin resistance may also play a role in MAFLD. Insulin-resistant skeletal muscle is not as efficient at taking up glucose from the bloodstream after a meal.[19] This inefficient glucose uptake promotes the redistribution of consumed carbohydrates from glucose destined for use in glycogen stores in the skeletal muscles to being used as a substrate for de novo lipogenesis in the liver.[19]
Dysbiosis
Disruptions in the intestinal microbiota seem to influence NAFLD risk in several ways.[56] People with NASH can have elevated levels of blood ethanol and Pseudomonadota (which produce alcohol), with dysbiosis proposed as a mechanism for this elevation.[57] Alterations in the composition of the intestinal microbiota may influence NAFLD risk in several ways. These changes appear to increase the permeability of intestinal tissue, thereby facilitating increased liver exposure to harmful substances (e.g., translocated bacteria, bacterial toxins, and inflammatory chemical signals). The increased transport of these harmful substances to the liver promotes liver inflammation, enhances nutrient and calorie absorption, and alters choline metabolism.[57][58][59] Higher levels of intestinal bacteria that produce butyrate may be protective.[57]
Excessive macronutrient intake contributes to gut inflammation and perturbation of homeostasis, and micronutrients may also be involved.[60] In addition to reducing weight and risk factors, lifestyle changes may prompt positive changes in the gut microbiota.[61] In particular, diet diversity may play a role that was overlooked in animal studies, since they often compare a Western high-fat, low-diversity diet against a low-fat but higher-diversity chow.[62] The health benefits after bariatric surgery may also involve changes in the gut microbiota by increasing gut permeability.[62]


 NASH (inflammation) and fibrosis stage 1
NASH (inflammation) and fibrosis stage 1 NASH (inflammation) and fibrosis stage 2
NASH (inflammation) and fibrosis stage 2 Lobular inflammation
Lobular inflammation
Diagnosis

NAFLD is defined by the presence of excess fat in the liver that cannot be explained by another factor, such as excessive alcohol use (>21 standard drinks/week for men and >14 for women in the USA; >30 g daily for men and >20 g for women in UK and EU, >140 g/week for men and >70 g/week for women in Asia-Pacific), liver injury caused by drugs or toxins or viruses, nutritional deficiency, or endocrine conditions. In practice, diagnosis is often made simply based on the clinical presentation and a lack of high-volume alcohol consumption reported by the patient, but this is an unreliable method of diagnosis and should be confirmed with other methods whenever possible.[3][5][7][63][16][64]
NAFLD comprises two histological categories: NAFL, and the more aggressive form NASH. The presence of at least 5% fatty liver is common to both NAFL and NASH, but the features of substantial lobular inflammation and hepatocyte injuries such as ballooning or Mallory hyaline only occur in NASH. The majority of NAFL cases show minimal or no inflammation.[3][5][7] Pericentral and perisinusoidal fibrosis occur more often in adult-onset NASH, whereas portal fibrosis is more common in children with the disorder. NASH represents a more advanced stage of NAFL and is associated with poor outcomes such as cardiovascular events, cirrhosis, or hepatocellular carcinoma. ICD-11 does not use the term NAFL as it was deemed confusing with the family of disorders NAFLD. The preferred descriptions are instead: MAFLD without NASH or simple steatosis and "NASH". Also, the modifier with or without fibrosis or cirrhosis completes the diagnostic description.[3][7]
Blood tests
Liver function tests may be abnormal, but they often remain within the normal range even in advanced disease.[13][63][24] Other blood tests that may be useful to confirm the diagnosis include erythrocyte sedimentation rate, serum glucose, and albumin. Because the liver is important for making proteins used in blood clotting, coagulation-related studies are often carried out, especially the prothrombin time. In people with fatty liver with associated inflammatory injury (steatohepatitis) blood tests are usually used to rule out certain types of viral hepatitis and autoimmune diseases. Low thyroid activity is more prevalent in people with NASH, which would be detected by determining the thyroid-stimulating hormone.[65] Some biomarker-based blood tests have been developed and may be useful for diagnosis.[66]
Although blood tests cannot diagnose MAFLD, circulating serum biomarkers of liver fibrosis can give moderate estimates in the diagnosis of liver fibrosis and cirrhosis. The ratio of the transaminase liver enzyme aspartate aminotransferase (AST) to platelets in the blood, known as the AST/platelet ratio index (APRI score), and Fibrotest are recommended as the preferred noninvasive tests for cirrhosis by the Asian-Pacific Association for Study of the Liver (APASL).[67] Several other scores such as FIB-4 score and NAFLD fibrosis score can also reflect the burden of the fibrosis in the liver,[68] and previous studies have confirmed that these scores can predict future development of mortality and liver cancer.[69]
Imaging

A liver ultrasound scan or magnetic resonance imaging (MRI) can diagnose steatosis,[70] but not fibrosis and confirmation of early cirrhosis detection by ultrasound by other diagnostic methods is recommended.[67] The European Association for the Study of the Liver (EASL) recommends screening for steatosis whenever NAFLD is suspected as this is a strong predictor of the disease evolution and predicts future type 2 diabetes, cardiovascular events, and hypertension.[16] These non-invasive methods can be used for NAFLD screening but are not accepted as a substitute for liver biopsy in NAFLD nor NASH clinical trials, as only a liver biopsy can define liver pathology.[7][14]
Ultrasound presented average sensitivity and specificity for diagnosing the disease in children, while in the adult population, sensitivity and specificity were significantly higher. Proton density fat fraction magnetic resonance imaging has been increasingly used for the diagnosis of steatosis in pediatric patients.
Ultrasound elastography is an effective tool for staging liver fibrosis and discriminating NASH from MAFLD in children.[71]
Computerized tomography and magnetic resonance imaging are more accurate in detecting cirrhosis than conventional ultrasound.[67] Transient elastography is recommended for the initial assessment of liver fibrosis and cirrhosis and helps to predict complications and prognosis, but the interpretation of results is carefully weighed in the presence of limiting factors such as steatosis, high BMI, low amount of hepatic fibrosis, narrow spaces between the ribs, and portal hypertension. Transient elastography is not a substitute for liver biopsy.[67]
Magnetic resonance elastography (MRE) is an established method that can accurately assess hepatic fibrosis and is recommended by the APASL, AGA, ACR and AASLD.[67] MRE possesses excellent accuracy to detect fibrosis in NAFLD regardless of BMI and inflammation, and is suggested as a more reliable alternative to diagnose NAFLD and its progression to NASH compared to ultrasound and blood tests.[27][32][72][73]
Liver biopsy


A liver biopsy (tissue examination) is the only test widely accepted (gold standard) as definitively diagnosing and distinguishing NAFLD (including NAFL and NASH) from other forms of liver disease and can be used to assess the severity of the inflammation and resultant fibrosis. However, since most people affected by NAFLD are likely to be asymptomatic, liver biopsy presents too high a risk for routine diagnosis, so other methods are preferred, such as liver ultrasonography or liver MRI. For young people, guidelines recommend liver ultrasonography, but biopsy remains the best evidence.[5][7][63][27] Liver biopsy is also the gold standard to detect hepatic fibrosis and assess its progression.[67] Routine liver function blood tests are not sensitive enough to detect MAFLD, and biopsy is the only procedure that can reliably differentiate NAFL from NASH.[16]
There are several liver biopsy techniques available to obtain liver tissue. Percutaneous liver biopsy remains the most common practice. Biopsies can also be performed via the transvenous route, either during surgery or by laparoscopy, especially for people with contraindications to a percutaneous approach. The liver biopsy can also be image-guided, in real-time or not, which is recommended for some clinical situations such as people with known intra-hepatic lesions, previous intra-abdominal surgery who may have adhesions, a small liver that is difficult to percuss, obese people and people with evident ascites. Vital signs must be monitored frequently afterward (at least every 15 minutes in the hour following the biopsy).[67]
According to AASLD guidelines, a liver biopsy may be considered in people with NAFLD who are at increased risk of having steatohepatitis with or without advanced fibrosis, but only when all other competing chronic liver diseases are excluded (such as alcoholic liver disease). The presence of metabolic syndrome, NAFLD Fibrosis Score (FIB-4), or liver stiffness (as measured by Vibration-controlled transient elastography or MRE) can identify the individuals who are at higher risk of steatohepatitis or advanced fibrosis.[5]
| score | ||||
|---|---|---|---|---|
| 0 | 1 | 2 | 3 | |
| Steatosis | <5% | 5- 33% | >33- 66% | >66% |
| Lobular inflammation | None | <2 foci | 2- 4 foci | >4 foci |
| Hepatocyte ballooning |
None | Few | Many/prominent | |
The AASLD and ICD-11 consider that clinically useful pathology reporting distinguishes "between NAFL (steatosis), NAFL with inflammation and NASH (steatosis with lobular and portal inflammation and hepatocellular ballooning)" with the presence or absence of fibrosis being described and optionally comment on severity.[5][7] The EASL recommends the Fatty Liver Inhibition of Progression (FLIP) algorithm to grade the ballooning and classify MAFLD-associated liver injury, and the use of the NAFLD Activity Score (NAS) to grade the severity of NASH rather than for its diagnosis. They also consider the steatosis, activity, and fibrosis (SAF) score to be an accurate and reproducible scoring system.[16] The AASLD recommends the use of the NAS scoring system with or without the SAF score if deemed appropriate.[5] The Asia-Pacific Working Group on MAFLD disadvises the use of NAS, as it is considered uninformative for NAFLD and inappropriate to diagnose NASH.[14]
For liver fibrosis assessment, percutaneous liver biopsy, with or without image guidance, is contraindicated in uncooperative people.[67] Transjugular liver biopsy is indicated for any person with diffuse liver disease who needs a biopsy but has a contraindication to percutaneous biopsy or needs a hemodynamic evaluation for diagnostic purposes. A transvenous liver biopsy is recommended instead of a percutaneous approach in people with clinically evident ascites, although percutaneous biopsy is an acceptable alternative approach after the removal of ascites.[67]
Management
NAFLD warrants treatment regardless of whether the affected person is overweight or not.[7] MAFLD is a preventable cause of death.[23] Guidelines are available from the American Association for the Study of Liver Diseases (AASLD), American Association of Clinical Endocrinologists (AACE) National Institute for Health and Care Excellence (NICE), the European Association for the Study of the Liver (EASL), and the Asia-Pacific Working Party on NAFLD.[5][7][14][63][16][75][76]
Lifestyle
Weight loss is the most effective treatment for NAFLD. A loss of 4% to 10% body weight is recommended, with 10% to 40% weight loss completely reversing NASH without cirrhosis. A structured weight loss program helps people with MAFLD lose more weight compared with advice alone. This type of program also leads to improvements in NAFLD measured using blood tests, ultrasound, imaging, or liver biopsies. Although fibrosis improves with lifestyle interventions and weight loss, there is limited evidence for cirrhosis improvement.[7][14][75][77]
A combination of improved diet and exercise, rather than either alone, appears to best help manage NAFLD and reduce insulin resistance.[5][15][16][78][79] Motivational support, such as with cognitive behavioral therapy, is helpful, as most people with MAFLD do not perceive their condition as a disease, and thus have a low motivation to change.[5][13][63][16][47]
Higher-intensity behavioral weight loss therapies (diet and exercise combined) may produce more weight loss than lower-intensity ones. A 2019 systematic review suggested a change of guidelines to recommend these therapies for MAFLD management. Weight loss is associated with improvements in biomarkers, MAFLD grade, and reduced chances of NASH, but its effect on long-term health was not known.[77]
2021 meta-analyses of trials over periods of 1 to 28 months found limited evidence to indicate that lifestyle modifications and nutritional supplementation have an effect on mortality, liver cirrhosis, liver decompensation, liver transplantation, and hepatocellular carcinoma in people with non-alcohol-related fatty liver disease; authors said that it was unlikely that differences in clinical outcomes would become apparent in trials with less than 5 years to 10 years of follow‐up, and that sample sizes needed to be much larger than had been used.[80][81]
Diet
Treatment of NAFLD typically involves counseling to improve nutrition and calorie restriction.[13][75][82] People with NAFLD can benefit from a moderate to low-carbohydrate diet and a low-fat diet.[13][83] The Mediterranean diet also showed promising results in a 6-week study with a reduction of NASH induced inflammation and fibrosis, independently from weight loss.[13][16][79][84] Tentative evidence supports dietary interventions in individuals with fatty liver who are not overweight.[85]
The EASL recommends energy restriction of 500–1000 kcal per week less than the normal daily diet, a target of 7–10% weight loss for obese/overweight MAFLD, a low- to moderate-fat, and moderate- to high-carbohydrate diet, or a low-carbohydrate ketogenic or high-protein diet such as the Mediterranean diet, and avoiding all beverages and food containing fructose.[16]
Alcohol is an aggravating factor, and the AASLD recommends that people with NAFLD or NASH avoid alcohol consumption.[5][13][63][86] The EASL allows alcohol consumption below 30g/day for men and 20g/day for women.[16] The role of coffee consumption for NAFLD treatment is unclear though some studies indicate that regular coffee consumption may have protective effects.[16][87][88]
Herbal compounds such as silymarin (a milk thistle seed extract),[89] curcumin, a turmeric extract,[90] and green tea appear to improve NAFLD biomarkers and reduce the grade of NAFLD.[52] Studies suggest an association between microscopic organisms that inhabit the gut (microbiota) and MAFLD. Reviews reported the use of probiotics and synbiotics (combinations of probiotics and prebiotics) were associated with improvement in liver-specific markers of hepatic inflammation, measurements of liver stiffness, and steatosis in persons with MAFLD.[91][92]
Vitamin E does not improve established liver fibrosis in those with MAFLD but seems to improve certain markers of liver function and reduces inflammation and fattiness of the liver in some people with MAFLD.[5][13][63] The Asia-Pacific Work Group advises that Vitamin E may improve liver condition and aminotransferase levels, but only in adults without diabetes or cirrhosis who have NASH.[14] The NICE guidelines recommend Vitamin E as an option for children and adults with NAFLD with advanced liver fibrosis, regardless of whether the person has diabetes mellitus.[13][63]
Physical activity
Weight loss may improve MAFLD and is recommended particularly for obese or overweight people;[93][94][95] similar physical activities and diets are advisable for overweight people with MAFLD as for other obese and overweight people.[63][79] Although physical activity is less important for weight loss than dietary adaptations (to reduce caloric intake),[47] the NICE advises physical activity to reduce liver fat even if there is no overall bodyweight reduction.[13][63] Weight loss, through exercise or diet, is the most effective way to reduce liver fat and help NASH and fibrosis remission.[47] Exercise alone can prevent or reduce hepatic steatosis, but it remains unknown whether it can improve all other aspects of the liver; hence a combined approach with diet and exercise is advised.[5][15] Aerobic exercise may be more effective than resistance training, although there are contradictory results.[13][96] Vigorous training is preferable to moderate training, as only the high-intensity exercise reduced the chances of MAFLD developing into NASH or advanced fibrosis.[13][97] The EASL recommends between 150 and 200 min/week in 3 to 5 sessions of moderate-intensity aerobic physical activity or resistance training. Since both effectively reduce liver fat, a pragmatic approach to the choice of physical activity that accounts for the individual's preferences for what they can maintain in the long-term is preferred. Any engagement in physical activity or increase over previous levels is better than remaining sedentary.[16]
Medication
While many treatments appear to improve biochemical markers such as alanine transaminase levels, most do not reverse histological abnormalities or improve outcomes.[5][14][98] Treatment with medications is primarily aimed at improving liver disease and is generally limited to those with biopsy-proven NASH and fibrosis.[5][63][16]
Insulin sensitizers (metformin and thiazolidinediones, such as pioglitazone) are not specifically recommended for MAFLD as they do not directly improve the liver condition. They can be indicated for diabetic individuals, after a careful assessment of risks, to reduce insulin resistance and risks of complications.[5][14] Indeed, the side effects associated with thiazolidinedione medications, which include osteopenia, increased fracture risk, fluid retention, congestive heart failure, bladder cancer, and long-term weight gain, have limited their adoption.[13][99][100] Due to these side effects, the AASLD recommends the use of pioglitazone only for individuals with biopsy-proven NASH, and the Asia-Pacific Work Group recommends them only for individuals with MAFLD with known diabetic issues. However, the AASLD advises against the use of metformin as studies were inconclusive about the improvement of the liver's histological condition. Although there was an improvement in insulin resistance and serum aminotransferases, this did not translate into NASH improvements.[5] The NICE provides similar guidelines to the AASLD regarding pioglitazone and recommends it be administered in secondary care to adults with advanced liver fibrosis irrespective of whether or not they have diabetes.[63]
Glucagon-like peptide-1 receptor agonists are at least as effective as pioglitazone and Vitamin E and significantly reduce steatosis, ballooning necrosis, lobular inflammation, and fibrosis according to a 2023 systematic review.[18]
Statin medications appear to improve liver histology and markers of liver biochemistry in people with MAFLD. Since people with NAFLD are at a higher risk of cardiovascular disease, statin treatment is indicated. People with NAFLD are not at higher risk for serious liver injury from statins, according to AASLD and EASL. However, even if statins are safe to use in people with NASH cirrhosis, the AASLD suggests avoiding them in people with decompensated cirrhosis.[5][16][101] Guidelines recommend statins to treat dyslipidemia for people with MAFLD. According to NICE guidelines, statins can continue unless liver enzyme levels double within three months of starting statins.[63] Treatment with pentoxifylline is not recommended.[14]
Omega-3 fatty acids may reduce liver fat and improve blood lipid profile but do not seem to improve liver histology (fibrosis, cirrhosis, cancer).[14] The NICE does not recommend omega-3 fatty acid supplementation since randomized trials were inconclusive.[13][63] Previous systematic reviews found that omega-3 fatty acid supplementation in those with MAFLD/NASH using doses of one gram daily or more (median dose four grams/day with median treatment duration six months) has been associated with improvements in liver fat.[47][102] According to AASLD guidelines, "omega-3 fatty acids should not be used as a specific treatment of NAFLD or NASH, but they may be considered to treat hypertriglyceridemia for patients with NAFLD".[5]
Resmetirom (Rezdiffra) was approved for medical use in the United States in March 2024 for the treatment of noncirrhotic nonalcoholic steatohepatitis.[103][104]
Aspirin, 81 mg for 6 months, significantly reduced hepatic fat quantity compared with placebo among 40 randomized participants with MASLD in a 6-month, phase 2, randomized, double-blind clinical trial conducted at a single hospital in Boston, Massachusetts. [105]
Surgery

Bariatric surgery is an effective method for obese and diabetic individuals with MAFLD to induce weight loss and reduce or resolve NASH inflammation, including fibrosis, and improve longevity.[13][14][16][47][106][107] For the AASLD, bariatric surgery can be considered only for NASH on a case-by-case basis by an experienced bariatric surgery program.[5] Indeed, some individuals might develop new or worsened features of MAFLD.[107]
About 92% of people with MAFLD saw an improvement in steatosis and 70% a complete resolution after bariatric surgery.[108]
A preoperative diet such as a low-calorie diet or a very-low-calorie diet is usually recommended to reduce liver volume by 16–20%. Preoperative weight loss is the only factor associated with postoperative weight loss.[109][110] Preoperative weight loss can reduce operative time and hospital stay,[109][111][112] although there is insufficient evidence whether preoperative weight loss reduces long-term morbidity or complications.[112][113] Weight loss and decreases in liver size may be independent of the amount of calorie restriction.[110]
The APWG on MAFLD recommends bariatric surgery as a treatment option for those with class II obesity (BMI >32.5 kg/m2 for Asians, 35 kg/m2 for Caucasians). They consider its effects on improving liver-related complications as unproven yet, but it effectively increases longevity by improving cardiovascular factors.[14]
Surgery carries more risks for individuals with NASH cirrhosis, with a review estimating overall morbidity to be 21%. For people with MAFLD who have undifferentiated cirrhosis, the APWG recommends an investigation to determine the cause of the cirrhosis as well as the person's liver function and whether they have portal hypertension.[14]
Screening
Cardiovascular system screening is considered mandatory by the EASL, as MAFLD outcomes often result in cardiovascular complications,[16] which can manifest as subclinical atherosclerosis, the cause of the majority of MAFLD-related deaths.[50][114] People with MAFLD are at high risk for cardiovascular morbidity and mortality, and "aggressive modification of cardiovascular disease risk factors is warranted in all patients with NAFLD," according to AASLD.[5]
The AASLD further recommends for people with a cirrhotic NASH to be systematically screened for gastric and esophageal varices and liver cancer. They do not recommend routine liver biopsies and screening for liver cancer for non-cirrhotic people with NASH, but such screening sometimes occurs on a case-by-case basis.[5]
Also, people with MAFLD may be considered for screening for hepatocellular carcinoma (liver cancer) and gastroesophageal varices. The NICE advises regular screening of NAFLD for advanced liver fibrosis every three years to adults and every two years for children using the enhanced liver fibrosis (ELF) blood test.[63] Follow-up is recommended for people with obesity and insulin resistance using the homeostasis model assessment of insulin resistance (HOMA-IR). People with NASH with fibrosis and hypertension merit closer monitoring as there is a higher risk of disease progression.[16]
Transplantation
MAFLD is the second most common indication for liver transplantation in the US and Europe as of 2017.[14] MAFLD/NASH is expected to become the leading cause of liver transplantation by 2020.[115]
For people with NASH and end-stage liver disease, liver failure, or liver cancer, liver transplantation is an accepted procedure according to the EASL.[16] People with NASH cirrhosis NASH who are being considered for a liver transplant warrant systematic evaluation for cardiovascular diseases (whether the symptoms are apparent or not).[5]
The overall survival is comparable to transplantation following other diseases.[14][16] People with NASH cirrhosis who undergo liver transplantation are more likely to die post-transplant because of cardiovascular disease or chronic kidney disease. These people with NASH are often older and are thus more prone to these complications.[14] For these reasons and others, individuals with morbid obesity (BMI ≥ 40 kg/m2) and NASH with cirrhosis may be considered unfit for liver transplantation until they follow lifestyle modifications to reduce bodyweight.[14] Diabetic people with poor glycemic control are at similar risks, and optimal glycemic control is essential before attempting transplantation.[14]
The Asia Pacific Working Group guidelines recommend healthcare providers discuss lifestyle modifications before and after transplantation to reduce potential surgery risks and to assist with MAFLD management after the transplant.[14]
Simultaneous bariatric surgery and liver transplantation were performed in exceptional circumstances.[14]
After transplantation, liver biopsy is the best method to monitor the evolution of post-transplant fibrosis, with significant fibrosis or portal hypertension one year after transplantation predicting rapid progression and graft loss and indicating the need for urgent intervention.[67]
Prognosis
The average progression rate from one stage of liver fibrosis to the next in humans with NASH is estimated to be seven years, compared to 14 years with MAFLD. The course of progression varies with different clinical manifestations among individuals.[24][26][116] Fibrosis in humans with NASH progressed more rapidly than in humans with MAFLD.[13] Obesity predicts a worse long-term outcome than for lean individuals.[117][118] In the Asia-Pacific region, about 25% of MAFLD cases progress to NASH under three years, but only a low proportion (3.7%) develop advanced liver fibrosis.[7] An international study showed that people with MAFLD with advanced fibrosis had a 10-year survival rate of 81.5%.[5]
MAFLD is a risk factor for fibrosis, hypertension, chronic kidney disease, atrial fibrillation, myocardial infarction, ischemic stroke, and death from cardiovascular causes based on very-low to low-quality evidence from observational studies.[63][119] Although MAFLD can cause cirrhosis and liver failure and liver cancer, most deaths among people with NAFLD are attributable to cardiovascular disease.[50] According to a meta-analysis of 34,000 people with MAFLD over seven years, these individuals have a 65% increased risk of developing fatal or nonfatal cardiovascular events when compared to those without MAFLD.[26]
MAFLD and NASH increase the risk of liver cancer. Cirrhosis and liver cancer induced by NAFLD were the second cause of liver transplantation in the US in 2017. Liver cancer develops in NASH in the absence of cirrhosis in 45% in the cases,[120] and people with NASH cirrhosis have an increased risk of liver cancer. The rate of liver cancer associated with NASH increased fourfold between 2002 and 2012 in the US, which is more than any other cause of liver cancer. MAFLD constitutes the third most common risk factor for liver cancer.[121] NAFLD and NASH were found to worsen with cirrhosis in respectively 2–3% and 15–20% of the people over a 10–20 year period.[13] Cirrhosis is found in only about 50% of people with MAFLD and with liver cancer, so that liver cancer and cirrhosis are not always linked.[14]
MAFLD may be a precursor of metabolic syndrome, although a bidirectional influence is possible.[122][123][124] The presence and stage of fibrosis are the strongest prognostic factors for liver-related events and mortality, in particular for MAFLD.[24]
Epidemiology

MAFLD incidence is rapidly rising, along with obesity and diabetes, and has become the most common cause of liver disease in developed countries, for adults, teenagers, and children.[23][24] The percentage of people with MAFLD ranges from 9 to 36.9% in different parts of the world.[125][126] Approximately 20% of the United States and 25% of the Asia-Pacific populations have non-alcoholic fatty liver.[7][21] Similar prevalence can be found in Europe, although less data is available.[24] MAFLD is the most common in the Middle East (32%) and South America (30%), while Africa has the lowest rates (13%).[5][24] Compared to the 2000s, NAFL and NASH respectively increased 2-fold and 2.5-fold in the 2010s in the USA.[127]
MAFLD and NASH are more prevalent in Hispanics - which can be attributed to high rates of obesity and type 2 diabetes in Hispanic populations, intermediate in Whites, and lowest in Blacks.[22][24][128] NAFLD was observed to be twice as prevalent in men as women.[5] For severely obese individuals, the prevalence of MAFLD rises over 90%, and for those with diabetes, over 60%, and up to 20% for normal-weight people.[24][25] MAFLD is present in 65% to 90% of people that had bariatric surgery, and up to 75% of them have NASH.[14] Ultrasonography and proton NMR spectroscopy studies suggest about 25% of the population seems to be affected by MAFLD or NASH.[7][24]
Although the disease is commonly associated with obesity, a significant proportion of those affected are normal weight or lean. Lean MAFLD affects between 10 and 20% of Americans and Europeans, and approximately 25% of Asians, although some countries have a higher incidence (e.g., India has a very high proportion of lean MAFLD and almost no obese MAFLD). PNPLA3 may be relevant for the progression of MAFLD in lean people. Thus, people with MAFLD deserve consideration for treatment regardless of the presence or absence of obesity.[7][24][47][117]
In children ages 1 to 19, the prevalence was found to be approximately 8% in the general population up to 34% in studies with data from child obesity clinics.[129]
The majority of cryptogenic cirrhosis is believed to be due to NASH.[7] NAFLD prevalence is expected to increase steadily,[130] from 25% in 2018 to a projected 33.5% of people with MAFLD globally in 2030, and from 20% to a projected 27% of those with MAFLD will progress to NASH.[131]
History
The first acknowledged case of obesity-related non-alcoholic fatty liver was observed in 1952 by Samuel Zelman.[132][133] Zelman started investigating after observing a fatty liver in a hospital employee who drank more than twenty bottles of Coca-Cola a day. He then went on to design a trial for a year and a half on 20 obese people who were not alcoholic, finding that about half of them had substantially fatty livers.[132] Fatty liver was, however, linked to diabetes since at least 1784[134] — an observation picked up again in the 1930s.[135] Studies in experimental animals implicated choline inadequacy in the 1920s and excess sugar consumption in 1949.[136]
The name "non-alcoholic steatohepatitis" (NASH) was later defined in 1980 by Jurgen Ludwig and his colleagues from the Mayo Clinic[137] to raise awareness of the existence of this pathology, as similar reports previously were dismissed as "patients' lies".[133] This paper was mostly ignored at the time but eventually came to be seen as a landmark paper, and starting in the mid-1990s, the condition began to be intensively studied, with a series of international meetings being held on the topic since 1998.[138] The broader NAFLD term started to be used around 2002.[138][139] Diagnostic criteria began to be worked out, and in 2005 the Pathology Committee of the NIH NASH Clinical Research Network proposed the NAS scoring system.[138]
Society and culture
Political recommendations
EASL recommends Europe's public health authorities to "restrict advertising and marketing of sugar-sweetened beverages and industrially processed foods high in saturated fat, sugar, and salt", as well as "fiscal measures to discourage the consumption of sugar-sweetened beverages and legislation to ensure that the food industry improves labeling and the composition of processed foods", as well as "public awareness campaigns on liver disease, highlighting that it is not only linked to excessive consumption of alcohol".[130]
Media
In France, the French syndicate of non-alcoholic beverages "Boissons Rafraîchissantes de France" (that included soft drink producers such as Coca-Cola France, Orangina, PepsiCo France) was denounced by the French journal fr:Canard Enchainé for misleading consumers using a communication on their website titled "Better understanding the NASH pathology",[140] explaining that "NASH pathology is sometimes called the soda illness by language abuse or an unfortunate semantic shortcut, as it is not directly linked to the consumption of non-alcoholic beverages". This page and others on the same website, such as one titled "Say no to disinformation," were since then removed.[141]
Children
Pediatric MAFLD was first reported in 1983.[142][143] It is the most common chronic liver disease among children and adolescents since at least 2007, affecting 10 to 20% of them in the US in 2016.[24][143][144] MAFLD is associated with metabolic syndrome, which is a cluster of risk factors that contribute to the development of cardiovascular disease and type 2 diabetes mellitus. Studies have demonstrated that abdominal obesity and insulin resistance, in particular, are significant contributors to the development of NAFLD.[145][146][147][148][149] Coexisting liver diseases, such as hepatitis C and cardiovascular diseases such as atherosclerosis, are also associated with an increased risk of NAFLD.[27][50] Some children were diagnosed as early as two years old, with a mean age of diagnosis between 11 and 13 years old.[143] The mean age is usually above 10 years, as children can also report non-specific symptoms and are thus difficult to diagnose for MAFLD.[143]
Boys are more likely to be diagnosed with MAFLD than girls.[27][129] Overweight, or even weight gain, in childhood and adolescence, is associated with an increased risk of MAFLD later in life, with adult NAFLD predicted in a 31-year follow-up study by risk factors during childhood including BMI, plasma insulin levels, male sex, genetic background (PNPLA3 and TM6SF2 variants) and low birth weight, an emerging risk factor for adulthood MAFLD.[24][27] In a study, simple steatosis was present in up to 45% in children with a clinical suspicion of MAFLD.[27] Children with simple steatosis have a worse prognosis than adults, with significantly more of them progressing from NAFLD to NASH compared to adults. Indeed, 17-25% of children with MAFLD develop a NASH in general, and up to 83% for children with severe obesity (versus 29% for adults), further suggesting that hepatic fibrosis seems to follow a more aggressive clinical course in children compared to adults.[143]
Early diagnosis of MAFLD in children may help prevent the development of liver disease during adulthood.[147][150] This is challenging as most children with MAFLD are asymptomatic, with only 42-59% showing abdominal pain.[27][150] Other symptoms might be present, such as right upper quadrant pain or acanthosis nigricans, the latter of which is often present in children with NASH. An enlarged liver occurs in 30–40% of children with NAFLD.[27]
The AASLD recommends a diagnostic liver biopsy in children when the diagnosis is unclear or before starting a potentially hepatotoxic medical therapy.[5] The EASL suggests using fibrosis tests such as elastography, acoustic radiation force impulse imaging, and serum biomarkers to reduce the number of biopsies.[16] In follow up, NICE guidelines recommend that healthcare providers offer children regular MAFLD screening for advanced liver fibrosis every two years using the enhanced liver fibrosis (ELF) blood test.[63] Several studies also suggest magnetic resonance elastography as an alternative to the less reliable ultrasonography.[27]
Intensive lifestyle modifications, including physical activity and dietary changes, are the first line of treatment according to AASLD and EASL as it improves the liver histology and aminotransferase levels. In terms of pharmacological treatment, the AASLD and EASL do not recommend metformin, but vitamin E may improve liver health for some children.[5][16] The NICE advises the use of vitamin E for children with advanced liver fibrosis, whether they have diabetes or not.[63] The only treatment shown to be effective in childhood MAFLD is weight loss.[151]
Some evidence indicates that maternal undernutrition or overnutrition increases a child's susceptibility to NASH and hastens its progression.[152]
Research
Diagnosis and biomarkers
Since a MAFLD diagnosis based on a liver biopsy is invasive and makes it difficult to estimate epidemiology, it is a high research priority to find accurate, inexpensive, and noninvasive methods of diagnosing and monitoring MAFLD disease and its progression.[32][153] The search for these biomarkers of MAFLD, NAFL, and NASH involves lipidomics, medical imaging, proteomics, blood tests, and scoring systems.[32]
According to a review, proton density fat fraction estimation by magnetic resonance imaging (MRI-PDFF) may be considered the most accurate and even gold standard test to quantify hepatic steatosis. They recommend ultrasound-based transient elastography to accurately diagnose both fibrosis and cirrhosis in a routine clinical setting, with more objectivity than ultrasonography but with lower accuracy than magnetic resonance elastography; and plasma cytokeratin 18 (CK18) fragment levels to be a moderately accurate biomarker of steatohepatitis.[32] However, transient elastography can fail for people with pre-hepatic portal hypertension.[67]
Medication development

A variety of medications with different mechanisms of action have been tested in clinical trials.[154] Clinical trials can be separated into four main targets believed to reduce the progression of the disease or reverse it:[155]
- Improving metabolism (improving insulin sensitivity, inhibiting de novo lipogenesis, or increasing fatty acid oxidation).[155] Metabolic modulators tested in NASH include glucagon-like peptide-1 receptor agonists (GLP-1 agonists), GLP-1 and glucose-dependent insulinotropic polypeptide (GIP) or glucagon co-agonists and thyromimetics. Some of these drugs may treat NAFLD by significantly reducing body weight.[156]
- Reducing inflammation, for example reducing oxidative stress and hepatocyte death.[155] These drugs, such as chemokine antagonists, anti-apoptotics, vascular adhesion protein-1 inhibitors, and c-Jun N-terminal kinase inhibitors, have not shown benefit.[156]
- "Gut-liver axis targets" that either change a person's microbiome, or act on bile acids[155]
- Anti-fibrotic drugs,[155] such as fibroblast growth factor analogues, which have largely not met their endpoints[156]
Other treatments such as farnesoid X receptor (FXR) agonists, peroxisome proliferator-activated receptor (PPAR) agonists, and ASK1 (apoptosis signal-regulating kinase 1) inhibitors may improve NAFLD by multiple mechanisms simultaneously.[156] Drugs in phase III trials as of 2023 are obeticholic acid (a FXR agonist), the thyromimetic resmetirom, lanifibranor (a pan-PPAR agonist), and the GLP-1 agonist semaglutide.[154]
Notes
- ↑ In 2023, a global consensus panel composed mostly of hepatology researchers and clinicians recommended a change of name to Metabolic dysfunction–associated steatotic liver disease (MASLD).[1][10][11] The term metabolic (dysfunction) associated fatty liver disease (MAFLD) has also been used.[2] The umbrella term steatotic liver disease (SLD) covers MASLD, alcoholic liver disease (ALD) and MetALD, a term describing people with MASLD who consume more than 140 grams of alcohol per week for women and 210 grams per week for men (an in-between MASLD and ALD).[1][10]
References
- 1 2 3 4 5 6 7 8 9 Rinella ME, Lazarus JV, Ratziu V, Francque SM, Sanyal AJ, Kanwal F, et al. (December 2023). "A multisociety Delphi consensus statement on new fatty liver disease nomenclature". Hepatology. 78 (6): 1966–1986. doi:10.1097/HEP.0000000000000520. PMC 10653297. PMID 37363821. S2CID 259260747.
- 1 2 Eslam M, Sanyal AJ, George J (May 2020). "MAFLD: A Consensus-Driven Proposed Nomenclature for Metabolic Associated Fatty Liver Disease". Gastroenterology. 158 (7): 1999–2014.e1. doi:10.1053/j.gastro.2019.11.312. PMID 32044314.
- 1 2 3 4 5 6 7 8 "DB92 Non-alcoholic fatty liver disease". WHO. 18 June 2018. Retrieved 2 October 2019.
- 1 2 3 4 5 6 7 8 9 "Nonalcoholic Fatty Liver Disease & NASH". National Institute of Diabetes and Digestive and Kidney Diseases. 7 November 2018. Retrieved 2 April 2020.
- 1 2 3 4 5 6 7 8 9 10 11 12 13 14 15 16 17 18 19 20 21 22 23 24 25 26 27 28 29 30 31 32 33 34 35 36 37 Chalasani N, Younossi Z, Lavine JE, Charlton M, Cusi K, Rinella M, et al. (January 2018). "The diagnosis and management of nonalcoholic fatty liver disease: Practice guidance from the American Association for the Study of Liver Diseases". Hepatology (Professional society guidelines). 67 (1): 328–357. doi:10.1002/hep.29367. hdl:1805/14037. PMID 28714183.
- ↑ Jensen T, Abdelmalek MF, Sullivan S, Nadeau KJ, Green M, Roncal C, et al. (May 2018). "Fructose and sugar: A major mediator of non-alcoholic fatty liver disease". Journal of Hepatology. 68 (5): 1063–1075. doi:10.1016/j.jhep.2018.01.019. PMC 5893377. PMID 29408694.
- 1 2 3 4 5 6 7 8 9 10 11 12 13 14 15 16 17 18 19 20 21 Wong VW, Chan WK, Chitturi S, Chawla Y, Dan YY, Duseja A, et al. (January 2018). "Asia-Pacific Working Party on Non-alcoholic Fatty Liver Disease guidelines 2017-Part 1: Definition, risk factors and assessment". Journal of Gastroenterology and Hepatology (Professional society guidelines). 33 (1): 70–85. doi:10.1111/jgh.13857. PMID 28670712.
- 1 2 3 4 Iser D, Ryan M (July 2013). "Fatty liver disease--a practical guide for GPs". Australian Family Physician. 42 (7): 444–447. PMID 23826593.
- ↑ Dulai PS, Singh S, Patel J, Soni M, Prokop LJ, Younossi Z, et al. (May 2017). "Increased risk of mortality by fibrosis stage in nonalcoholic fatty liver disease: Systematic review and meta-analysis". Hepatology. 65 (5): 1557–1565. doi:10.1002/hep.29085. PMC 5397356. PMID 28130788.
- 1 2 3 Smith J (13 July 2023). "A Liver Disease Gets a New Name, Diagnostic Criteria". Medscape.
- ↑ "Advances in MASLD/NAFLD - call for manuscript submissions". Nature - communications medicine. 2023.
- 1 2 Loomba R, Wong VW (January 2024). "Implications of the new nomenclature of steatotic liver disease and definition of metabolic dysfunction-associated steatotic liver disease". Alimentary Pharmacology & Therapeutics. 59 (2): 150–156. doi:10.1111/apt.17846. PMC 10807722. PMID 38153279. S2CID 266561981.
- 1 2 3 4 5 6 7 8 9 10 11 12 13 14 15 16 17 18 Rinella ME, Sanyal AJ (April 2016). "Management of NAFLD: a stage-based approach". Nature Reviews. Gastroenterology & Hepatology. 13 (4): 196–205. doi:10.1038/nrgastro.2016.3. PMID 26907882. S2CID 26643913.
- 1 2 3 4 5 6 7 8 9 10 11 12 13 14 15 16 17 18 19 20 21 22 23 24 Chitturi S, Wong VW, Chan WK, Wong GL, Wong SK, Sollano J, et al. (January 2018). "The Asia-Pacific Working Party on Non-alcoholic Fatty Liver Disease guidelines 2017-Part 2: Management and special groups". Journal of Gastroenterology and Hepatology (Professional society guidelines). 33 (1): 86–98. doi:10.1111/jgh.13856. PMID 28692197. S2CID 29648173.
- 1 2 3 Kenneally S, Sier JH, Moore JB (1 June 2017). "Efficacy of dietary and physical activity intervention in non-alcoholic fatty liver disease: a systematic review". BMJ Open Gastroenterology. 4 (1): e000139. doi:10.1136/bmjgast-2017-000139. PMC 5508801. PMID 28761689.
- 1 2 3 4 5 6 7 8 9 10 11 12 13 14 15 16 17 18 19 20 21 22 23 24 European Association for the Study of the Liver (EASL), European Association for the Study of Diabetes (EASD), European Association for the Study of Obesity (EASO) (June 2016). "EASL-EASD-EASO Clinical Practice Guidelines for the management of non-alcoholic fatty liver disease". Journal of Hepatology (Professional society guidelines). 64 (6): 1388–1402. doi:10.1016/j.jhep.2015.11.004. PMC 5644799. PMID 27062661.
- Lay summary in: Spahr L, Goossens N (25 January 2017). "La stéatopathie non alcoolique". Revue Médicale Suisse (in French). doi:10.53738/REVMED.2017.13.547.0215.
- ↑ "Treatment for NAFLD & NASH - NIDDK". National Institute of Diabetes and Digestive and Kidney Diseases. Retrieved 16 September 2023.
- 1 2 Gu Y, Sun L, He Y, Yang L, Deng C, Zhou R, et al. (March 2023). "Comparative efficacy of glucagon-like peptide 1 (GLP-1) receptor agonists, pioglitazone and vitamin E for liver histology among patients with nonalcoholic fatty liver disease: systematic review and pilot network meta-analysis of randomized controlled trials". Expert Review of Gastroenterology & Hepatology. 17 (3): 273–282. doi:10.1080/17474124.2023.2172397. PMID 36689199. S2CID 256102760.
- 1 2 3 4 5 6 7 8 9 10 11 12 13 14 15 16 17 18 19 Marjot T, Moolla A, Cobbold JF, Hodson L, Tomlinson JW (January 2020). "Nonalcoholic Fatty Liver Disease in Adults: Current Concepts in Etiology, Outcomes, and Management". Endocrine Reviews. 41 (1): 66–117. doi:10.1210/endrev/bnz009. PMID 31629366.
- 1 2 Younossi ZM, Koenig AB, Abdelatif D, Fazel Y, Henry L, Wymer M (July 2016). "Global epidemiology of nonalcoholic fatty liver disease-Meta-analytic assessment of prevalence, incidence, and outcomes". Hepatology. 64 (1): 73–84. doi:10.1002/hep.28431. PMID 26707365.
- 1 2 Rinella ME (June 2015). "Nonalcoholic fatty liver disease: a systematic review". JAMA (Systematic review). 313 (22): 2263–2273. doi:10.1001/jama.2015.5370. hdl:2318/1636665. PMID 26057287.
- 1 2 Rich NE, Oji S, Mufti AR, Browning JD, Parikh ND, Odewole M, et al. (February 2018). "Racial and Ethnic Disparities in Nonalcoholic Fatty Liver Disease Prevalence, Severity, and Outcomes in the United States: A Systematic Review and Meta-analysis". Clinical Gastroenterology and Hepatology. 16 (2): 198–210.e2. doi:10.1016/j.cgh.2017.09.041. PMC 5794571. PMID 28970148.
- 1 2 3 4 "Obesity epidemic results in Non-Alcoholic Fatty Liver Disease (NAFLD) becoming the most common cause of liver disease in Europe". EASL-The Home of Hepatology. 25 September 2019. Archived from the original on 5 October 2019. Retrieved 5 October 2019.
- 1 2 3 4 5 6 7 8 9 10 11 12 13 14 15 16 17 18 19 20 Younossi Z, Anstee QM, Marietti M, Hardy T, Henry L, Eslam M, et al. (January 2018). "Global burden of NAFLD and NASH: trends, predictions, risk factors and prevention". Nature Reviews. Gastroenterology & Hepatology. 15 (1): 11–20. doi:10.1038/nrgastro.2017.109. hdl:2318/1659230. PMID 28930295. S2CID 31345431.
- 1 2 Younossi ZM (March 2019). "Non-alcoholic fatty liver disease - A global public health perspective". Journal of Hepatology. 70 (3): 531–544. doi:10.1016/j.jhep.2018.10.033. PMID 30414863.
- 1 2 3 4 5 6 Friedman SL, Neuschwander-Tetri BA, Rinella M, Sanyal AJ (July 2018). "Mechanisms of NAFLD development and therapeutic strategies". Nature Medicine. 24 (7): 908–922. doi:10.1038/s41591-018-0104-9. PMC 6553468. PMID 29967350.
- 1 2 3 4 5 6 7 8 9 10 AlKhater SA (May 2015). "Paediatric non-alcoholic fatty liver disease: an overview". Obesity Reviews. 16 (5): 393–405. doi:10.1111/obr.12271. PMID 25753407. S2CID 39735609.
- ↑ Tilg H, Moschen AR, Roden M (January 2017). "NAFLD and diabetes mellitus". Nature Reviews. Gastroenterology & Hepatology. 14 (1): 32–42. doi:10.1038/nrgastro.2016.147. PMID 27729660. S2CID 22213841.
- ↑ Musso G, Cassader M, Olivetti C, Rosina F, Carbone G, Gambino R (May 2013). "Association of obstructive sleep apnoea with the presence and severity of non-alcoholic fatty liver disease. A systematic review and meta-analysis". Obesity Reviews. 14 (5): 417–431. doi:10.1111/obr.12020. hdl:2318/127880. PMID 23387384. S2CID 31153416.
- ↑ Singh A, Hussain S, Antony B (2021). "Non-alcoholic fatty liver disease and clinical outcomes in patients with COVID-19: A comprehensive systematic review and meta-analysis". Diabetes & Metabolic Syndrome. 15 (3): 813–822. doi:10.1016/j.dsx.2021.03.019. PMC 8011308. PMID 33862417.
- ↑ Ballestri S, Nascimbeni F, Baldelli E, Marrazzo A, Romagnoli D, Lonardo A (June 2017). "NAFLD as a Sexual Dimorphic Disease: Role of Gender and Reproductive Status in the Development and Progression of Nonalcoholic Fatty Liver Disease and Inherent Cardiovascular Risk". Advances in Therapy. 34 (6): 1291–1326. doi:10.1007/s12325-017-0556-1. PMC 5487879. PMID 28526997.
- 1 2 3 4 5 6 Wong VW, Adams LA, de Lédinghen V, Wong GL, Sookoian S (August 2018). "Noninvasive biomarkers in NAFLD and NASH - current progress and future promise". Nature Reviews. Gastroenterology & Hepatology. 15 (8): 461–478. doi:10.1038/s41575-018-0014-9. PMID 29844588. S2CID 44102990.
- 1 2 Lim JS, Mietus-Snyder M, Valente A, Schwarz JM, Lustig RH (May 2010). "The role of fructose in the pathogenesis of NAFLD and the metabolic syndrome". Nature Reviews. Gastroenterology & Hepatology. 7 (5): 251–264. doi:10.1038/nrgastro.2010.41. PMID 20368739. S2CID 2483983.
- ↑ Wree A, Broderick L, Canbay A, Hoffman HM, Feldstein AE (November 2013). "From NAFLD to NASH to cirrhosis-new insights into disease mechanisms". Nature Reviews. Gastroenterology & Hepatology. 10 (11): 627–636. doi:10.1038/nrgastro.2013.149. PMID 23958599. S2CID 6899033.
- ↑ Leermakers ET, Moreira EM, Kiefte-de Jong JC, Darweesh SK, Visser T, Voortman T, et al. (August 2015). "Effects of choline on health across the life course: a systematic review". Nutrition Reviews. 73 (8): 500–522. doi:10.1093/nutrit/nuv010. PMID 26108618.
- ↑ Li H, Zheng X, Sabina R, Amrish T, Meng G, Zhang Q, et al. (July 2023). "Organ meat consumption and risk of non-alcoholic fatty liver disease: the Tianjin Chronic Low-grade Systemic Inflammation and Health cohort study". The British Journal of Nutrition. 130 (2): 276–283. doi:10.1017/S0007114522000629. PMID 35225189.
- ↑ Ivancovsky-Wajcman D, Fliss-Isakov N, Grinshpan LS, Salomone F, Lazarus JV, Webb M, et al. (August 2022). "High Meat Consumption Is Prospectively Associated with the Risk of Non-Alcoholic Fatty Liver Disease and Presumed Significant Fibrosis". Nutrients. 14 (17): 3533. doi:10.3390/nu14173533. PMC 9459934. PMID 36079791.
- ↑ Hashemian M, Merat S, Poustchi H, Jafari E, Radmard AR, Kamangar F, et al. (August 2021). "Red Meat Consumption and Risk of Nonalcoholic Fatty Liver Disease in a Population With Low Meat Consumption: The Golestan Cohort Study". The American Journal of Gastroenterology. 116 (8): 1667–1675. doi:10.14309/ajg.0000000000001229. PMC 8460710. PMID 33767101.
- ↑ Mokhtari Z, Poustchi H, Eslamparast T, Hekmatdoost A (April 2017). "Egg consumption and risk of non-alcoholic fatty liver disease". World Journal of Hepatology. 9 (10): 503–509. doi:10.4254/wjh.v9.i10.503. PMC 5387362. PMID 28443155.
- ↑ Zhang S, Meng G, Zhang Q, Liu L, Yao Z, Wu H, et al. (September 2021). "Consumption of Preserved Egg Is Associated with Modestly Increased Risk of Nonalcoholic Fatty Liver Disease in Chinese Adults". The Journal of Nutrition. 151 (9): 2741–2748. doi:10.1093/jn/nxab163. PMID 34049388.
- ↑ Zhang S, Fu J, Zhang Q, Liu L, Meng G, Yao Z, et al. (September 2019). "Association between nut consumption and non-alcoholic fatty liver disease in adults". Liver International. 39 (9): 1732–1741. doi:10.1111/liv.14164. PMID 31162803. S2CID 174806063.
- ↑ Bahrami A, Teymoori F, Eslamparast T, Sohrab G, Hejazi E, Poustchi H, et al. (February 2019). "Legume intake and risk of nonalcoholic fatty liver disease". Indian Journal of Gastroenterology. 38 (1): 55–60. doi:10.1007/s12664-019-00937-8. PMID 30796701. S2CID 73509821.
- ↑ Li X, Peng Z, Li M, Zeng X, Li H, Zhu Y, et al. (October 2022). "A Healthful Plant-Based Diet Is Associated with Lower Odds of Nonalcoholic Fatty Liver Disease". Nutrients. 14 (19): 4099. doi:10.3390/nu14194099. PMC 9572274. PMID 36235752.
- ↑ Mazidi M, Kengne AP (August 2019). "Higher adherence to plant-based diets are associated with lower likelihood of fatty liver". Clinical Nutrition. 38 (4): 1672–1677. doi:10.1016/j.clnu.2018.08.010. PMID 30578029. S2CID 58667804.
- ↑ Tanné F, Gagnadoux F, Chazouillères O, Fleury B, Wendum D, Lasnier E, et al. (June 2005). "Chronic liver injury during obstructive sleep apnea". Hepatology. 41 (6): 1290–1296. doi:10.1002/hep.20725. PMID 15915459.
- ↑ Wang H, Gao Q, He S, Bao Y, Sun H, Meng L, et al. (June 2020). "Self-reported snoring is associated with nonalcoholic fatty liver disease". Scientific Reports. 10 (1): 9267. Bibcode:2020NatSR..10.9267W. doi:10.1038/s41598-020-66208-1. PMC 7283303. PMID 32518245.
- 1 2 3 4 5 6 7 Marchesini G, Petta S, Dalle Grave R (June 2016). "Diet, weight loss, and liver health in nonalcoholic fatty liver disease: Pathophysiology, evidence, and practice". Hepatology. 63 (6): 2032–2043. doi:10.1002/hep.28392. hdl:10447/159316. PMID 26663351. S2CID 19914572.
- ↑ Khan RS, Newsome PN (February 2018). "NAFLD in 2017: Novel insights into mechanisms of disease progression". Nature Reviews. Gastroenterology & Hepatology. 15 (2): 71–72. doi:10.1038/nrgastro.2017.181. PMID 29300050. S2CID 10248663.
- ↑ Della Pepa G, Vetrani C, Lombardi G, Bozzetto L, Annuzzi G, Rivellese AA (September 2017). "Isocaloric Dietary Changes and Non-Alcoholic Fatty Liver Disease in High Cardiometabolic Risk Individuals". Nutrients. 9 (10): 1065. doi:10.3390/nu9101065. PMC 5691682. PMID 28954437.
- 1 2 3 4 Byrne CD, Targher G (April 2015). "NAFLD: a multisystem disease". Journal of Hepatology. 62 (1 Suppl): S47–S64. doi:10.1016/j.jhep.2014.12.012. PMID 25920090.
- ↑ Zhang X, Ji X, Wang Q, Li JZ (February 2018). "New insight into inter-organ crosstalk contributing to the pathogenesis of non-alcoholic fatty liver disease (NAFLD)". Protein & Cell. 9 (2): 164–177. doi:10.1007/s13238-017-0436-0. PMC 5818366. PMID 28643267.
- 1 2 Bagherniya M, Nobili V, Blesso CN, Sahebkar A (April 2018). "Medicinal plants and bioactive natural compounds in the treatment of non-alcoholic fatty liver disease: A clinical review". Pharmacological Research. 130: 213–240. doi:10.1016/j.phrs.2017.12.020. PMID 29287685. S2CID 207369426.
- 1 2 3 Palmer AK, Gustafson B, Kirkland JL, Smith U (October 2019). "Cellular senescence: at the nexus between ageing and diabetes". Diabetologia. 62 (10): 1835–1841. doi:10.1007/s00125-019-4934-x. PMC 6731336. PMID 31451866.
- ↑ Vacca M, Leslie J, Virtue S, Lam BY, Govaere O, Tiniakos D, et al. (June 2020). "Bone morphogenetic protein 8B promotes the progression of non-alcoholic steatohepatitis". Nature Metabolism. 2 (6): 514–531. doi:10.1038/s42255-020-0214-9. hdl:10044/1/82228. PMID 32694734. S2CID 219933429.
- ↑ Lustig RH (September 2010). "Fructose: metabolic, hedonic, and societal parallels with ethanol". Journal of the American Dietetic Association. 110 (9): 1307–1321. doi:10.1016/j.jada.2010.06.008. PMID 20800122.
- ↑ Tokuhara D (25 June 2021). "Role of the Gut Microbiota in Regulating Non-alcoholic Fatty Liver Disease in Children and Adolescents". Frontiers in Nutrition. 8: 700058. doi:10.3389/fnut.2021.700058. PMC 8267179. PMID 34250000.
- 1 2 3 Leung C, Rivera L, Furness JB, Angus PW (July 2016). "The role of the gut microbiota in NAFLD". Nature Reviews. Gastroenterology & Hepatology. 13 (7): 412–425. doi:10.1038/nrgastro.2016.85. PMID 27273168. S2CID 24114749.
- ↑ Mehal WZ (November 2013). "The Gordian Knot of dysbiosis, obesity and NAFLD". Nature Reviews. Gastroenterology & Hepatology. 10 (11): 637–644. doi:10.1038/nrgastro.2013.146. PMID 23958600. S2CID 20972307.
- ↑ Sharpton SR, Ajmera V, Loomba R (January 2019). "Emerging Role of the Gut Microbiome in Nonalcoholic Fatty Liver Disease: From Composition to Function". Clinical Gastroenterology and Hepatology. 17 (2): 296–306. doi:10.1016/j.cgh.2018.08.065. PMC 6314895. PMID 30196156.
- ↑ Pickett-Blakely O, Young K, Carr RM (2018). "Micronutrients in Nonalcoholic Fatty Liver Disease Pathogenesis". Cellular and Molecular Gastroenterology and Hepatology. 6 (4): 451–462. doi:10.1016/j.jcmgh.2018.07.004. PMC 6170520. PMID 30294653.
- ↑ Panasevich MR, Peppler WT, Oerther DB, Wright DC, Rector RS (August 2017). "Microbiome and NAFLD: potential influence of aerobic fitness and lifestyle modification". Physiological Genomics. 49 (8): 385–399. doi:10.1152/physiolgenomics.00012.2017. PMID 28600319.
- 1 2 Heiman ML, Greenway FL (May 2016). "A healthy gastrointestinal microbiome is dependent on dietary diversity". Molecular Metabolism (Review). 5 (5): 317–320. doi:10.1016/j.molmet.2016.02.005. PMC 4837298. PMID 27110483.
Stable, diverse and healthy GI microbial ecosystems are an important component to consider when using diet to perturb physiological systems in animal models of disease, and it is an aspect often overlooked. A common model to study obesity and insulin resistance is one in which the diet is switched from a basic chow diet to a "Western" or "high fat" diet with a predominance of fat and sugar.
- 1 2 3 4 5 6 7 8 9 10 11 12 13 14 15 16 17 18 "NG49: Non-alcoholic fatty liver disease (NAFLD): assessment and management | Guidance and guidelines". NICE. July 2016. Glen J, Floros L, Day C, Pryke R (September 2016). "Non-alcoholic fatty liver disease (NAFLD): summary of NICE guidance". BMJ (National guidelines). 354: i4428. doi:10.1136/bmj.i4428. PMID 27605111. S2CID 32302328.
- ↑ Toshikuni N, Tsutsumi M, Arisawa T (July 2014). "Clinical differences between alcoholic liver disease and nonalcoholic fatty liver disease". World Journal of Gastroenterology. 20 (26): 8393–8406. doi:10.3748/wjg.v20.i26.8393. PMC 4093692. PMID 25024597.
- ↑ Liangpunsakul S, Chalasani N (October 2003). "Is hypothyroidism a risk factor for non-alcoholic steatohepatitis?". Journal of Clinical Gastroenterology. 37 (4): 340–343. doi:10.1097/00004836-200310000-00014. PMID 14506393. S2CID 41849572.
- ↑ Musso G, Gambino R, Cassader M, Pagano G (December 2011). "Meta-analysis: natural history of non-alcoholic fatty liver disease (NAFLD) and diagnostic accuracy of non-invasive tests for liver disease severity". Annals of Medicine. 43 (8): 617–649. doi:10.3109/07853890.2010.518623. PMID 21039302. S2CID 207470810.
- 1 2 3 4 5 6 7 8 9 10 11 Shiha G, Ibrahim A, Helmy A, Sarin SK, Omata M, Kumar A, et al. (January 2017). "Asian-Pacific Association for the Study of the Liver (APASL) consensus guidelines on invasive and non-invasive assessment of hepatic fibrosis: a 2016 update". Hepatology International (Professional society guidelines). 11 (1): 1–30. doi:10.1007/s12072-016-9760-3. PMID 27714681.
- ↑ Peleg N, Issachar A, Sneh-Arbib O, Shlomai A (October 2017). "AST to Platelet Ratio Index and fibrosis 4 calculator scores for non-invasive assessment of hepatic fibrosis in patients with non-alcoholic fatty liver disease". Digestive and Liver Disease. 49 (10): 1133–1138. doi:10.1016/j.dld.2017.05.002. PMID 28572039.
- ↑ Peleg N, Sneh Arbib O, Issachar A, Cohen-Naftaly M, Braun M, Shlomai A (2018). Vespasiani-Gentilucci U (ed.). "Noninvasive scoring systems predict hepatic and extra-hepatic cancers in patients with nonalcoholic fatty liver disease". PLOS ONE. 13 (8): e0202393. Bibcode:2018PLoSO..1302393P. doi:10.1371/journal.pone.0202393. PMC 6091950. PMID 30106985.
- ↑ Vilgrain V, Ronot M, Abdel-Rehim M, Zappa M, d'Assignies G, Bruno O, et al. (2012). "Hepatic steatosis: a major trap in liver imaging". Diagnostic and Interventional Imaging (Tutorial). 94 (7–8): 713–727. doi:10.1016/j.diii.2013.03.010. PMID 23751229.
- ↑ Papachristodoulou A, Kavvadas D, Karamitsos A, Papamitsou T, Chatzidimitriou M, Sioga A (June 2021). "Diagnosis and Staging of Pediatric Non-Alcoholic Fatty Liver Disease: Is Classical Ultrasound the Answer?". Pediatric Reports. 13 (2): 312–321. doi:10.3390/pediatric13020039. PMC 8293345. PMID 34201230.
- ↑ Singh S, Venkatesh SK, Loomba R, Wang Z, Sirlin C, Chen J, et al. (May 2016). "Magnetic resonance elastography for staging liver fibrosis in non-alcoholic fatty liver disease: a diagnostic accuracy systematic review and individual participant data pooled analysis". European Radiology (Systematic review). 26 (5): 1431–1440. doi:10.1007/s00330-015-3949-z. PMC 5051267. PMID 26314479.
- ↑ Srinivasa Babu A, Wells ML, Teytelboym OM, Mackey JE, Miller FH, Yeh BM, et al. (2015). "Elastography in Chronic Liver Disease: Modalities, Techniques, Limitations, and Future Directions". Radiographics (Review). 36 (7): 1987–2006. doi:10.1148/rg.2016160042. PMC 5584553. PMID 27689833.
- ↑ Brunt EM, Kleiner DE, Carpenter DH, Rinella M, Harrison SA, Loomba R, et al. (May 2021). "NAFLD: Reporting Histologic Findings in Clinical Practice". Hepatology. 73 (5): 2028–2038. doi:10.1002/hep.31599. PMID 33111374. S2CID 233449144.
- 1 2 3 Garvey WT, Mechanick JI, Brett EM, Garber AJ, Hurley DL, Jastreboff AM, et al. (July 2016). "American Association of Clinical Endocrinologists and American College of Endocrinology Comprehensive Clinical Practice Guidelines for Medical Care of Patients with Obesity". Endocrine Practice (Professional society guidelines). 22 (Suppl 3): 1–203. doi:10.4158/EP161365.GL. PMID 27219496.
- ↑ Lonardo A, Nascimbeni F, Targher G, Bernardi M, Bonino F, Bugianesi E, et al. (May 2017). "AISF position paper on nonalcoholic fatty liver disease (NAFLD): Updates and future directions". Digestive and Liver Disease (Professional society guidelines). 49 (5): 471–483. doi:10.1016/j.dld.2017.01.147. hdl:2318/1636507. PMID 28215516.
- 1 2 Koutoukidis DA, Astbury NM, Tudor KE, Morris E, Henry JA, Noreik M, et al. (September 2019). "Association of Weight Loss Interventions With Changes in Biomarkers of Nonalcoholic Fatty Liver Disease: A Systematic Review and Meta-analysis". JAMA Internal Medicine. 179 (9): 1262–1271. doi:10.1001/jamainternmed.2019.2248. PMC 6604126. PMID 31260026.
- ↑ Paris T, George ES, Roberts SK, Tierney AC (August 2017). "The effects of diet and lifestyle interventions on insulin resistance in patients with nonalcoholic fatty liver disease: a systematic review". European Journal of Gastroenterology & Hepatology. 29 (8): 867–878. doi:10.1097/MEG.0000000000000890. PMID 28471823. S2CID 13768180.
- 1 2 3 Romero-Gómez M, Zelber-Sagi S, Trenell M (October 2017). "Treatment of NAFLD with diet, physical activity and exercise". Journal of Hepatology. 67 (4): 829–846. doi:10.1016/j.jhep.2017.05.016. PMID 28545937.
- ↑ Buzzetti E, Linden A, Best LM, Madden AM, Roberts D, Chase TJ, et al. (June 2021). "Lifestyle modifications for nonalcohol-related fatty liver disease: a network meta-analysis". The Cochrane Database of Systematic Reviews. 2021 (6): CD013156. doi:10.1002/14651858.cd013156.pub2. PMC 8193812. PMID 34114650.
- ↑ Komolafe O, Buzzetti E, Linden A, Best LM, Madden AM, Roberts D, et al. (July 2021). "Nutritional supplementation for nonalcohol-related fatty liver disease: a network meta-analysis". The Cochrane Database of Systematic Reviews. 2021 (7): CD013157. doi:10.1002/14651858.cd013157.pub2. PMC 8406904. PMID 34280304.
- ↑ Rusu E, Enache G, Jinga M, Dragut R, Nan R, Popescu H, et al. (2014). "Medical nutrition therapy in non-alcoholic fatty liver disease--a review of literature". Journal of Medicine and Life. 8 (3): 258–262. PMC 4556902. PMID 26351523.
- ↑ Hsu CC, Ness E, Kowdley KV (March 2017). "Nutritional Approaches to Achieve Weight Loss in Nonalcoholic Fatty Liver Disease". Advances in Nutrition. 8 (2): 253–265. doi:10.3945/an.116.013730. PMC 5347099. PMID 28298270.
- ↑ Zelber-Sagi S, Salomone F, Mlynarsky L (July 2017). "The Mediterranean dietary pattern as the diet of choice for non-alcoholic fatty liver disease: Evidence and plausible mechanisms". Liver International. 37 (7): 936–949. doi:10.1111/liv.13435. PMID 28371239.
- ↑ Merchant HA (September 2017). "Can Diet Help Non-Obese Individuals with Non-Alcoholic Fatty Liver Disease (NAFLD)?". Journal of Clinical Medicine. 6 (9): 88. doi:10.3390/jcm6090088. PMC 5615281. PMID 28925934.
- ↑ Veena J, Muragundla A, Sidgiddi S, Subramaniam S (December 2014). "Non-alcoholic fatty liver disease: need for a balanced nutritional source". The British Journal of Nutrition. 112 (11): 1858–1872. doi:10.1017/S0007114514002591. PMID 25274101.
- ↑ Tomic D, Kemp WW, Roberts SK (October 2018). "Nonalcoholic fatty liver disease: current concepts, epidemiology and management strategies". European Journal of Gastroenterology & Hepatology. 30 (10): 1103–1115. doi:10.1097/MEG.0000000000001235. PMID 30113367. S2CID 52010921.
- ↑ Wijarnpreecha K, Thongprayoon C, Ungprasert P (February 2017). "Coffee consumption and risk of nonalcoholic fatty liver disease: a systematic review and meta-analysis". European Journal of Gastroenterology & Hepatology. 29 (2): e8–e12. doi:10.1097/MEG.0000000000000776. PMID 27824642. S2CID 23243292.
- ↑ Zhong S, Fan Y, Yan Q, Fan X, Wu B, Han Y, et al. (December 2017). "The therapeutic effect of silymarin in the treatment of nonalcoholic fatty disease: A meta-analysis (PRISMA) of randomized control trials". Medicine. 96 (49): e9061. doi:10.1097/MD.0000000000009061. PMC 5728929. PMID 29245314.
- ↑ Jalali M, Mahmoodi M, Mosallanezhad Z, Jalali R, Imanieh MH, Moosavian SP (January 2020). "The effects of curcumin supplementation on liver function, metabolic profile and body composition in patients with non-alcoholic fatty liver disease: A systematic review and meta-analysis of randomized controlled trials". Complementary Therapies in Medicine. 48: 102283. doi:10.1016/j.ctim.2019.102283. PMID 31987259.
- ↑ Sharpton SR, Maraj B, Harding-Theobald E, Vittinghoff E, Terrault NA (July 2019). "Gut microbiome-targeted therapies in nonalcoholic fatty liver disease: a systematic review, meta-analysis, and meta-regression". The American Journal of Clinical Nutrition. 110 (1): 139–149. doi:10.1093/ajcn/nqz042. PMC 6599739. PMID 31124558.
- ↑ Hadi A, Mohammadi H, Miraghajani M, Ghaedi E (2019). "Efficacy of synbiotic supplementation in patients with nonalcoholic fatty liver disease: A systematic review and meta-analysis of clinical trials: Synbiotic supplementation and NAFLD". Critical Reviews in Food Science and Nutrition. 59 (15): 2494–2505. doi:10.1080/10408398.2018.1458021. PMID 29584449. S2CID 5006292.
- ↑ US Department of Health and Human Services. (2017). "2015–2020 Dietary Guidelines for Americans - health.gov". health.gov. Skyhorse Publishing Inc. Retrieved 30 September 2019.
- ↑ Arnett DK, Blumenthal RS, Albert MA, Buroker AB, Goldberger ZD, Hahn EJ, et al. (September 2019). "2019 ACC/AHA Guideline on the Primary Prevention of Cardiovascular Disease: A Report of the American College of Cardiology/American Heart Association Task Force on Clinical Practice Guidelines". Circulation. 140 (11): e596–e646. doi:10.1161/CIR.0000000000000678. PMC 7734661. PMID 30879355.
- ↑ Jensen MD, Ryan DH, Apovian CM, Ard JD, Comuzzie AG, Donato KA, et al. (June 2014). "2013 AHA/ACC/TOS guideline for the management of overweight and obesity in adults: a report of the American College of Cardiology/American Heart Association Task Force on Practice Guidelines and The Obesity Society". Circulation. 129 (25 Suppl 2): S102–S138. doi:10.1161/01.cir.0000437739.71477.ee. PMC 5819889. PMID 24222017.
- ↑ Hashida R, Kawaguchi T, Bekki M, Omoto M, Matsuse H, Nago T, et al. (January 2017). "Aerobic vs. resistance exercise in non-alcoholic fatty liver disease: A systematic review". Journal of Hepatology. 66 (1): 142–152. doi:10.1016/j.jhep.2016.08.023. PMID 27639843.
- ↑ Ratziu V (January 2017). "Non-pharmacological interventions in non-alcoholic fatty liver disease patients". Liver International. 37 (Suppl 1): 90–96. doi:10.1111/liv.13311. PMID 28052636.
- ↑ Ratziu V, Goodman Z, Sanyal A (April 2015). "Current efforts and trends in the treatment of NASH". Journal of Hepatology. 62 (1 Suppl): S65–S75. doi:10.1016/j.jhep.2015.02.041. PMID 25920092.
- ↑ Raziel A, Sakran N, Szold A, Goitein D (April 2015). "Current solutions for obesity-related liver disorders: non-alcoholic fatty liver disease and non-alcoholic steatohepatitis" (PDF). The Israel Medical Association Journal. 17 (4): 234–238. PMID 26040050.
- ↑ "Pour mieux soigner : des médicaments à écarter - actualisation 2018". www.prescrire.org. Prescrire. 25 January 2018.
- ↑ Chalasani N, Younossi Z, Lavine JE, Diehl AM, Brunt EM, Cusi K, et al. (June 2012). "The diagnosis and management of non-alcoholic fatty liver disease: practice guideline by the American Gastroenterological Association, American Association for the Study of Liver Diseases, and American College of Gastroenterology". Gastroenterology. 142 (7): 1592–1609. doi:10.1053/j.gastro.2012.04.001. PMID 22656328.
- ↑ Parker HM, Johnson NA, Burdon CA, Cohn JS, O'Connor HT, George J (April 2012). "Omega-3 supplementation and non-alcoholic fatty liver disease: a systematic review and meta-analysis". Journal of Hepatology (Systematic review and meta-analysis). 56 (4): 944–951. doi:10.1016/j.jhep.2011.08.018. PMID 22023985.
- ↑ "FDA Approves First Treatment for Patients with Liver Scarring Due to Fatty Liver Disease". U.S. Food and Drug Administration (FDA) (Press release). 14 March 2024. Retrieved 14 March 2024.
 This article incorporates text from this source, which is in the public domain.
This article incorporates text from this source, which is in the public domain. - ↑ "Madrigal Pharmaceuticals Announces FDA Approval of Rezdiffra (resmetirom) for the Treatment of Patients with Noncirrhotic Nonalcoholic Steatohepatitis (NASH) with Moderate to Advanced Liver Fibrosis". Madrigal Pharmaceuticals (Press release). 14 March 2024. Retrieved 14 March 2024.
- ↑ Simon TG, Wilechansky RM, Stoyanova S, Grossman A, Dichtel LE, Lauer GM, et al. (March 2024). "Aspirin for Metabolic Dysfunction-Associated Steatotic Liver Disease Without Cirrhosis: A Randomized Clinical Trial". JAMA. 331 (11): 920–929. doi:10.1001/jama.2024.1215. PMC 10951738. PMID 38502074.
- ↑ Lee Y, Doumouras AG, Yu J, Brar K, Banfield L, Gmora S, et al. (May 2019). "Complete Resolution of Nonalcoholic Fatty Liver Disease After Bariatric Surgery: A Systematic Review and Meta-analysis". Clinical Gastroenterology and Hepatology. 17 (6): 1040–1060.e11. doi:10.1016/j.cgh.2018.10.017. PMID 30326299.
- 1 2 Fakhry TK, Mhaskar R, Schwitalla T, Muradova E, Gonzalvo JP, Murr MM (March 2019). "Bariatric surgery improves nonalcoholic fatty liver disease: a contemporary systematic review and meta-analysis". Surgery for Obesity and Related Diseases. 15 (3): 502–511. doi:10.1016/j.soard.2018.12.002. PMID 30683512. S2CID 59275709.
- ↑ Mummadi RR, Kasturi KS, Chennareddygari S, Sood GK (December 2008). "Effect of bariatric surgery on nonalcoholic fatty liver disease: systematic review and meta-analysis". Clinical Gastroenterology and Hepatology. 6 (12): 1396–1402. doi:10.1016/j.cgh.2008.08.012. PMID 18986848.
- 1 2 Thorell A, MacCormick AD, Awad S, Reynolds N, Roulin D, Demartines N, et al. (September 2016). "Guidelines for Perioperative Care in Bariatric Surgery: Enhanced Recovery After Surgery (ERAS) Society Recommendations". World Journal of Surgery (Professional society guidelines). 40 (9): 2065–2083. doi:10.1007/s00268-016-3492-3. PMID 26943657.
- 1 2 Holderbaum M, Casagrande DS, Sussenbach S, Buss C (February 2018). "Effects of very low calorie diets on liver size and weight loss in the preoperative period of bariatric surgery: a systematic review". Surgery for Obesity and Related Diseases (Systematic review). 14 (2): 237–244. doi:10.1016/j.soard.2017.09.531. PMID 29239795.
- ↑ Livhits M, Mercado C, Yermilov I, Parikh JA, Dutson E, Mehran A, et al. (2008). "Does weight loss immediately before bariatric surgery improve outcomes: a systematic review". Surgery for Obesity and Related Diseases. 5 (6): 713–721. doi:10.1016/j.soard.2009.08.014. PMID 19879814.
- 1 2 Roman M, Monaghan A, Serraino GF, Miller D, Pathak S, Lai F, et al. (February 2019). "Meta-analysis of the influence of lifestyle changes for preoperative weight loss on surgical outcomes". The British Journal of Surgery (Meta-analysis). 106 (3): 181–189. doi:10.1002/bjs.11001. hdl:2381/43636. PMID 30328098.
- ↑ Cassie S, Menezes C, Birch DW, Shi X, Karmali S (2010). "Effect of preoperative weight loss in bariatric surgical patients: a systematic review". Surgery for Obesity and Related Diseases (Systematic review). 7 (6): 760–7, discussion 767. doi:10.1016/j.soard.2011.08.011. PMID 21978748.
- ↑ Zhou Y, Fu S (October 2017). "GW28-e0325 Association of non-alcoholic fatty liver disease and subclinical atherosclerosis: a systematic review and meta-analysis". Journal of the American College of Cardiology. 70 (16): C81. doi:10.1016/j.jacc.2017.07.284.
- ↑ Mahady SE, George J (August 2012). "Management of nonalcoholic steatohepatitis: an evidence-based approach". Clinics in Liver Disease. 16 (3): 631–645. doi:10.1016/j.cld.2012.05.003. PMID 22824485.
- ↑ Singh S, Allen AM, Wang Z, Prokop LJ, Murad MH, Loomba R (April 2015). "Fibrosis progression in nonalcoholic fatty liver vs nonalcoholic steatohepatitis: a systematic review and meta-analysis of paired-biopsy studies". Clinical Gastroenterology and Hepatology. 13 (4): 643–54.e1–9, quiz e39–40. doi:10.1016/j.cgh.2014.04.014. PMC 4208976. PMID 24768810.
- 1 2 Lu FB, Hu ED, Xu LM, Chen L, Wu JL, Li H, et al. (May 2018). "The relationship between obesity and the severity of non-alcoholic fatty liver disease: systematic review and meta-analysis". Expert Review of Gastroenterology & Hepatology. 12 (5): 491–502. doi:10.1080/17474124.2018.1460202. PMID 29609501. S2CID 4626474.
- ↑ Sookoian S, Pirola CJ (January 2018). "Systematic review with meta-analysis: the significance of histological disease severity in lean patients with nonalcoholic fatty liver disease". Alimentary Pharmacology & Therapeutics. 47 (1): 16–25. doi:10.1111/apt.14401. hdl:11336/86717. PMID 29083036.
- ↑ Usman MS, Siddiqi TJ (October 2017). "Emerging evidence for the association between non-alcoholic fatty liver disease and cardiac arrhythmias". Digestive and Liver Disease. 49 (10): 1166. doi:10.1016/j.dld.2017.07.013. PMID 28822729.
- ↑ Bellentani S (January 2017). "The epidemiology of non-alcoholic fatty liver disease". Liver International. 37 (Suppl 1): 81–84. doi:10.1111/liv.13299. PMID 28052624.
- ↑ Marengo A, Rosso C, Bugianesi E (14 January 2016). "Liver Cancer: Connections with Obesity, Fatty Liver, and Cirrhosis". Annual Review of Medicine. 67 (1): 103–117. doi:10.1146/annurev-med-090514-013832. hdl:2318/1636160. PMID 26473416.
- ↑ Lonardo A, Ballestri S, Marchesini G, Angulo P, Loria P (March 2015). "Nonalcoholic fatty liver disease: a precursor of the metabolic syndrome". Digestive and Liver Disease. 47 (3): 181–190. doi:10.1016/j.dld.2014.09.020. PMID 25739820.
- ↑ Yki-Järvinen H (November 2014). "Non-alcoholic fatty liver disease as a cause and a consequence of metabolic syndrome". The Lancet. Diabetes & Endocrinology. 2 (11): 901–910. doi:10.1016/S2213-8587(14)70032-4. PMID 24731669.
- ↑ Katsiki N, Perez-Martinez P, Anagnostis P, Mikhailidis DP, Karagiannis A (2018). "Is Nonalcoholic Fatty Liver Disease Indeed the Hepatic Manifestation of Metabolic Syndrome?". Current Vascular Pharmacology. 16 (3): 219–227. doi:10.2174/1570161115666170621075619. PMID 28669328.
- ↑ Omagari K, Kadokawa Y, Masuda J, Egawa I, Sawa T, Hazama H, et al. (October 2002). "Fatty liver in non-alcoholic non-overweight Japanese adults: incidence and clinical characteristics". Journal of Gastroenterology and Hepatology. 17 (10): 1098–1105. doi:10.1046/j.1440-1746.2002.02846.x. PMID 12201871. S2CID 23627555.
- ↑ Hilden M, Christoffersen P, Juhl E, Dalgaard JB (1977). "Liver histology in a 'normal' population--examinations of 503 consecutive fatal traffic casualties". Scandinavian Journal of Gastroenterology. 12 (5): 593–597. doi:10.3109/00365527709181339. PMID 918553.
- ↑ Kabbany MN, Conjeevaram Selvakumar PK, Watt K, Lopez R, Akras Z, Zein N, et al. (April 2017). "Prevalence of Nonalcoholic Steatohepatitis-Associated Cirrhosis in the United States: An Analysis of National Health and Nutrition Examination Survey Data". The American Journal of Gastroenterology. 112 (4): 581–587. doi:10.1038/ajg.2017.5. PMID 28195177. S2CID 39521696.
- ↑ Flegal KM, Carroll MD, Ogden CL, Johnson CL (October 2002). "Prevalence and trends in obesity among US adults, 1999-2000". JAMA. 288 (14): 1723–1727. doi:10.1001/jama.288.14.1723. PMID 12365955.
- 1 2 Anderson EL, Howe LD, Jones HE, Higgins JP, Lawlor DA, Fraser A (29 October 2015). "The Prevalence of Non-Alcoholic Fatty Liver Disease in Children and Adolescents: A Systematic Review and Meta-Analysis". PLOS ONE. 10 (10): e0140908. Bibcode:2015PLoSO..1040908A. doi:10.1371/journal.pone.0140908. PMC 4626023. PMID 26512983.
- 1 2 EASL (April 2019). "Policy Statement - Obesity is feeding the rise in Non-Alcoholic Fatty Liver Disease (NAFLD) across Europe" (PDF). Archived from the original (PDF) on 7 October 2019.
- ↑ Estes C, Razavi H, Loomba R, Younossi Z, Sanyal AJ (January 2018). "Modeling the epidemic of nonalcoholic fatty liver disease demonstrates an exponential increase in burden of disease". Hepatology. 67 (1): 123–133. doi:10.1002/hep.29466. PMC 5767767. PMID 28802062.
- 1 2 Zelman S (August 1952). "The liver in obesity". A.M.A. Archives of Internal Medicine. 90 (2): 141–156. doi:10.1001/archinte.1952.00240080007002. PMID 14943295.
- 1 2 Ludwig J, McGill DB, Lindor KD (May 1997). "Review: nonalcoholic steatohepatitis". Journal of Gastroenterology and Hepatology. 12 (5): 398–403. doi:10.1111/j.1440-1746.1997.tb00450.x. PMID 9195388. S2CID 34775647.
- ↑ Rabinowitch IM (June 1948). "Relationship between impairment of liver function and premature development of arteriosclerosis in diabetes mellitus". Canadian Medical Association Journal. 58 (6): 547–556. PMC 1590957. PMID 18862251.
- ↑ Hanssen P (14 March 1936). "Enlargement of the Liver in Diabetes Mellitus". Journal of the American Medical Association. 106 (11): 914. doi:10.1001/jama.1936.02770110030011.
- ↑ Best CH, Hartroft WS (November 1949). "Liver damage produced by feeding alcohol or sugar and its prevention by choline". British Medical Journal. 2 (4635): 1002–6, pl. doi:10.1136/bmj.2.4635.1001. PMC 2051633. PMID 15393035.
- ↑ Ludwig J, Viggiano TR, McGill DB, Oh BJ (July 1980). "Nonalcoholic steatohepatitis: Mayo Clinic experiences with a hitherto unnamed disease". Mayo Clinic Proceedings. 55 (7): 434–438. PMID 7382552.
- 1 2 3 Farrell GC, Larter CZ (February 2006). "Nonalcoholic fatty liver disease: from steatosis to cirrhosis". Hepatology. 43 (2 Suppl 1): S99–S112. doi:10.1002/hep.20973. PMID 16447287.
- ↑ Drew L (October 2017). "Fatty liver disease: turning the tide". Nature. 550 (7675): S101. doi:10.1038/550S101a. PMID 29019967.
- ↑ "Consommation et Nutrition - Boissons Rafraichissantes de France". Archived from the original on 25 April 2018.
- ↑ "Il était un foie le soda". No. 5102. Le Canard Enchaîné. August 2018.
- ↑ Moran JR, Ghishan FK, Halter SA, Greene HL (June 1983). "Steatohepatitis in obese children: a cause of chronic liver dysfunction". The American Journal of Gastroenterology. 78 (6): 374–377. PMID 6859017.
- 1 2 3 4 5 Temple JL, Cordero P, Li J, Nguyen V, Oben JA (June 2016). "A Guide to Non-Alcoholic Fatty Liver Disease in Childhood and Adolescence". International Journal of Molecular Sciences. 17 (6): 947. doi:10.3390/ijms17060947. PMC 4926480. PMID 27314342.
- ↑ Papandreou D, Rousso I, Mavromichalis I (August 2007). "Update on non-alcoholic fatty liver disease in children". Clinical Nutrition. 26 (4): 409–415. doi:10.1016/j.clnu.2007.02.002. PMID 17449148.
- ↑ Cortez-Pinto H, Camilo ME, Baptista A, De Oliveira AG, De Moura MC (December 1999). "Non-alcoholic fatty liver: another feature of the metabolic syndrome?". Clinical Nutrition. 18 (6): 353–358. doi:10.1016/S0261-5614(99)80015-6. PMID 10634920.
- ↑ Marchesini G, Brizi M, Bianchi G, Tomassetti S, Bugianesi E, Lenzi M, et al. (August 2001). "Nonalcoholic fatty liver disease: a feature of the metabolic syndrome". Diabetes. 50 (8): 1844–1850. doi:10.2337/diabetes.50.8.1844. PMID 11473047.
- 1 2 Nobili V, Marcellini M, Devito R, Ciampalini P, Piemonte F, Comparcola D, et al. (August 2006). "NAFLD in children: a prospective clinical-pathological study and effect of lifestyle advice". Hepatology. 44 (2): 458–465. doi:10.1002/hep.21262. PMID 16871574.
- ↑ Pagano G, Pacini G, Musso G, Gambino R, Mecca F, Depetris N, et al. (February 2002). "Nonalcoholic steatohepatitis, insulin resistance, and metabolic syndrome: further evidence for an etiologic association". Hepatology. 35 (2): 367–372. doi:10.1053/jhep.2002.30690. PMID 11826410.
- ↑ Schwimmer JB, Pardee PE, Lavine JE, Blumkin AK, Cook S (July 2008). "Cardiovascular risk factors and the metabolic syndrome in pediatric nonalcoholic fatty liver disease". Circulation. 118 (3): 277–283. doi:10.1161/CIRCULATIONAHA.107.739920. PMC 2996820. PMID 18591439.
- 1 2 Roberts EA (June 2007). "Pediatric nonalcoholic fatty liver disease (NAFLD): a "growing" problem?". Journal of Hepatology. 46 (6): 1133–1142. doi:10.1016/j.jhep.2007.03.003. PMID 17445934.
- ↑ Gibson PS, Lang S, Dhawan A, Fitzpatrick E, Blumfield ML, Truby H, et al. (August 2017). "Systematic Review: Nutrition and Physical Activity in the Management of Paediatric Nonalcoholic Fatty Liver Disease". Journal of Pediatric Gastroenterology and Nutrition. 65 (2): 141–149. doi:10.1097/MPG.0000000000001624. PMID 28737568.
- ↑ Wesolowski SR, Kasmi KC, Jonscher KR, Friedman JE (February 2017). "Developmental origins of NAFLD: a womb with a clue". Nature Reviews. Gastroenterology & Hepatology. 14 (2): 81–96. doi:10.1038/nrgastro.2016.160. PMC 5725959. PMID 27780972.
- ↑ Araújo AR, Rosso N, Bedogni G, Tiribelli C, Bellentani S (February 2018). "Global epidemiology of non-alcoholic fatty liver disease/non-alcoholic steatohepatitis: What we need in the future". Liver International. 38 (Suppl 1): 47–51. doi:10.1111/liv.13643. PMID 29427488.
- 1 2 Harrison SA, Loomba R, Dubourg J, Ratziu V, Noureddin M (July 2023). "Clinical Trial Landscape in NASH". Clinical Gastroenterology and Hepatology. 21 (8): 2001–2014. doi:10.1016/j.cgh.2023.03.041. PMID 37059159. S2CID 258115543.
- 1 2 3 4 5 Wang X (August 2022). "Challenges and opportunities in nonalcoholic steatohepatitis". Medical Review. 2 (4): 328–330. doi:10.1515/mr-2022-0024. PMC 10388777. PMID 37724322.
- 1 2 3 4 Ratziu V, Francque S, Sanyal A (June 2022). "Breakthroughs in therapies for NASH and remaining challenges". Journal of Hepatology. 76 (6): 1263–1278. doi:10.1016/j.jhep.2022.04.002. PMID 35589249. S2CID 248846797.